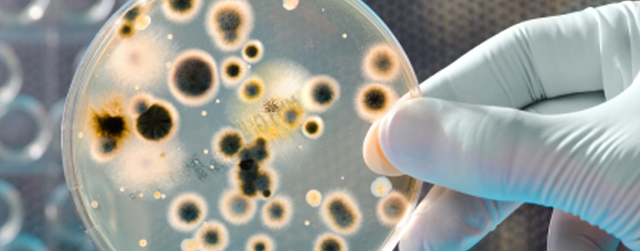

此前曾在国际空间站上发现细菌存活
新华社洛杉矶3月28日电 美国南加州大学28日宣布,该校科学家将与美国航天局喷气推进实验室的同行合作,把构巢曲霉这种真菌送到国际空间站,以便研发新药。
该校在一份声明中说,按计划,4月8日从美国卡纳维拉尔角发射的“龙”飞船将运送实验用的构巢曲霉至国际空间站。在太空高辐射、微重力的环境下,一些真菌将产生次级代谢物。
次级代谢物不仅对真菌自身生长繁殖起到重要作用,还可以用于制药。青霉素等抗生素就是次级代谢物,它在细菌、真菌或其他微生物的繁殖过程中产生,能够杀灭或抑制其他微生物。
编辑:sorazhang
新闻来源:http://tech.qq.com/a/20160330/024665.htm

留言